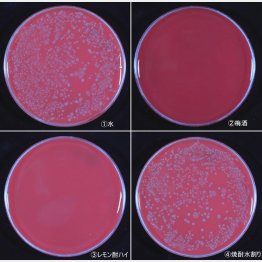

梅酒とレモンサワーで「食中毒」対策ができる? 高知大名誉教授が寄稿
米マクドナルドのハンバーガー、山梨県の焼き鳥店での白レバーとささみ、横浜市のデパートでのうなぎ弁当……。いずれも最近報じられた食中毒問題に関する食品だが、高知大学の松岡達臣名誉教授が食中毒に関する興味深い実験を行っている。その内容を寄稿してもらった。
■市販のレモン缶酎ハイで99%以上死滅
空腹時に口から入った微生物の多くは、pH1~2という強い酸性の胃酸によって胃の中で殺菌される。しかし、酸に対して耐性のある微生物は完全には殺菌されず、生き残ったものが腸に移行して食中毒の原因になる。
一方、弱い酸や、酒類に含まれるエタノール(エチルアルコール)は、単独では殺菌力が弱い。しかし弱い酸とエタノールを混ぜて「酸性エタノール」にすると、殺菌力が増大する。
筆者の実験では、塩酸(pH3)とエタノール(10%)の混合液で酸耐性の肺炎桿菌を懸濁処理(除菌効果の実験で最もよく行われる方法)。すると塩酸のみ、あるいはエタノールのみで処理した場合に比べて、菌の生存率は1万分の1以下にまで低下した。